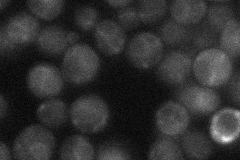
YBL082C

View description
Dolichol-P-Man dependent alpha(1-3) mannosyltransferase, involved in the synthesis of dolichol-linked oligosaccharide donor for N-linked glycosylation of proteins
Localization:
Intensity:
Fold change:
Significance:
-
C’ GFP library in SD

cytosol20.92 -
N' NOP1pr-GFP in SD

ER138.247 -
N' TEF2pr-mCherry in SD

ER223.747 -
N' NATIVEpr-GFP in SD
ER25.481 -
N' TEF2pr-VC and Cyto-VN in SD

ER45.6306 -
C’ GFP library in SD+DTT

cytosol20.170.96No -
C’ GFP library in SD+H2O2

cytosol18.370.87No -
C’ GFP library in Starvation Media

cytosol17.150.81No -
C’ GFP library on the background of Pup2-DaMP

cytosol -
C’ GFP library on the background of CCT mutant

cytosol23.06581.10194No
